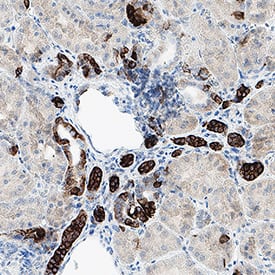

721 results for "Cytokeratin 7" in Products
Cytokeratin 7 Products
| Reactivity: | Human |
| Details: | Mouse IgG1 kappa Monoclonal Clone #K72.7 |
| Applications: | IHC, WB, ICC/IF, Flow, CyTOF-ready |
| Reactivity: | Human |
| Details: | Mouse IgG1 kappa Monoclonal Clone #K72.7 |
| Applications: | IHC |
| Reactivity: | Human |
| Details: | Mouse IgG1 kappa Monoclonal Clone #K72.7 |
| Applications: | IHC, WB, ICC/IF, Flow, CyTOF-ready |
| Reactivity: | Human |
| Details: | Mouse IgG1 kappa Monoclonal Clone #K72.7 |
| Applications: | IHC, WB, ICC/IF, Flow, CyTOF-ready |
| Reactivity: | Human |
| Details: | Mouse IgG1 kappa Monoclonal Clone #K72.7 |
| Applications: | IHC, WB, ICC/IF, Flow, CyTOF-ready |
Catalog #:
NBP2-47941AFP647
| Reactivity: | Human |
| Details: | Mouse IgG1 kappa Monoclonal Clone #K72.7 |
| Applications: | IHC, WB, ICC/IF, Flow, CyTOF-ready |
Catalog #:
NBP2-47941AFP405
| Reactivity: | Human |
| Details: | Mouse IgG1 kappa Monoclonal Clone #K72.7 |
| Applications: | IHC, WB, ICC/IF, Flow, CyTOF-ready |
Catalog #:
NBP2-47941AFP555
| Reactivity: | Human |
| Details: | Mouse IgG1 kappa Monoclonal Clone #K72.7 |
| Applications: | IHC, WB, ICC/IF, Flow, CyTOF-ready |
Catalog #:
NBP2-47941AFP680
| Reactivity: | Human |
| Details: | Mouse IgG1 kappa Monoclonal Clone #K72.7 |
| Applications: | IHC, WB, ICC/IF, Flow, CyTOF-ready |
Catalog #:
NBP2-47941AFP594
| Reactivity: | Human |
| Details: | Mouse IgG1 kappa Monoclonal Clone #K72.7 |
| Applications: | IHC, WB, ICC/IF, Flow, CyTOF-ready |
Catalog #:
NBP2-47941AFP488
| Reactivity: | Human |
| Details: | Mouse IgG1 kappa Monoclonal Clone #K72.7 |
| Applications: | IHC, WB, ICC/IF, Flow, CyTOF-ready |
| Reactivity: | Human, Mouse |
| Details: | Mouse IgG1 kappa Monoclonal Clone #OV-TL12/30 |
| Applications: | IHC, WB, ICC/IF, Flow, Simple Western |
| Reactivity: | Human |
| Details: | Mouse IgG1 kappa Monoclonal Clone #OV-TL12/30 |
| Applications: | IHC, WB, ICC/IF, Flow, CyTOF-ready, +1 More |
| Reactivity: | Human, Rat (Negative), Mouse (Negative), Rabbit (Negative), Ferret (Negative) |
| Details: | Mouse IgG1 kappa Monoclonal Clone #KRT7/903 |
| Applications: | IHC |
| Reactivity: | Human, Mouse, Rat |
| Details: | Rabbit IgG Polyclonal |
| Applications: | IHC, WB, Simple Western |
| Reactivity: | Human |
| Details: | Mouse IgG2b Monoclonal Clone #1090519 |
| Applications: | WB, IHC, ICC |
Recombinant Monoclonal Antibody
| Reactivity: | Human |
| Details: | Rabbit IgG Monoclonal Clone #3140B |
| Applications: | WB, Simple Western, IHC, ICC |
| Reactivity: | Human, Rat |
| Details: | Mouse IgG1 kappa Monoclonal Clone #KRT7/1198 |
| Applications: | IHC, WB, ICC/IF, Flow |
Recombinant Monoclonal Antibody
| Reactivity: | Human, Mouse, Rat |
| Details: | Rabbit IgG Monoclonal Clone #5V4M10 |
| Applications: | IHC, WB, ICC/IF |
| Reactivity: | Human |
| Details: | Mouse IgG1 Kappa/IgG1 Kappa Monoclonal Clone #KRT7/760 + KRT7/903 |
| Applications: | IHC, WB, ICC/IF, Flow, CyTOF-ready |
Catalog #:
FAB11626S
| Reactivity: | Human |
| Details: | Mouse IgG2b Monoclonal Clone #1090519 |
| Applications: | WB, IHC, ICC |
Catalog #:
FAB11626V
| Reactivity: | Human |
| Details: | Mouse IgG2b Monoclonal Clone #1090519 |
| Applications: | WB, IHC, ICC |
Catalog #:
FAB11626R
| Reactivity: | Human |
| Details: | Mouse IgG2b Monoclonal Clone #1090519 |
| Applications: | WB, IHC, ICC |
| Reactivity: | Human |
| Details: | Mouse IgG1 Kappa/IgG1 Kappa Monoclonal Clone #KRT7/760 + KRT7/903 |
| Applications: | IHC, WB, ICC/IF, Flow |
| Reactivity: | Human, Rat |
| Details: | Mouse IgG1 Kappa/IgG1 Kappa Monoclonal Clone #KRT7/760 + OV-TL12/30 |
| Applications: | IHC, WB, ICC/IF, Flow, CyTOF-ready |

![Western Blot: Cytokeratin 7 Antibody (K72.7)Azide and BSA Free [NBP2-47941] Western Blot: Cytokeratin 7 Antibody (K72.7)Azide and BSA Free [NBP2-47941]](https://resources.bio-techne.com/images/products/Cytokeratin-7-Antibody-K72-7-Azide-and-BSA-Free-Western-Blot-NBP2-47941-img0005.jpg)
![Immunohistochemistry-Paraffin: Cytokeratin 7 Antibody (K72.7) - IHC-Prediluted [NBP2-48125] Immunohistochemistry-Paraffin: Cytokeratin 7 Antibody (K72.7) - IHC-Prediluted [NBP2-48125]](https://resources.bio-techne.com/images/products/Cytokeratin-7-Antibody-K72-7-IHC-Prediluted-Immunohistochemistry-Paraffin-NBP2-48125-img0002.jpg)

![Product Feature: CoraFluor Probes for TR-FRET Cytokeratin 7 Antibody (K72.7) [CoraFluor™ 1]](https://resources.bio-techne.com/images/products/nbp2-47941cl1_mouse-cytokeratin-7-mab-k72-7-corafluor-1-81020251135250.png)
![Western Blot: Cytokeratin 7 Antibody (OV-TL12/30) [NBP2-44814] Western Blot: Cytokeratin 7 Antibody (OV-TL12/30) [NBP2-44814]](https://resources.bio-techne.com/images/products/Cytokeratin-7-Antibody-OV-TL12-30-Western-Blot-NBP2-44814-img0008.jpg)
![Western Blot: Cytokeratin 7 Antibody (OV-TL12/30)Azide and BSA Free [NBP2-47940] Western Blot: Cytokeratin 7 Antibody (OV-TL12/30)Azide and BSA Free [NBP2-47940]](https://resources.bio-techne.com/images/products/Cytokeratin-7-Antibody-OV-TL12-30-Azide-and-BSA-Free-Western-Blot-NBP2-47940-img0007.jpg)
![Immunohistochemistry-Paraffin: Cytokeratin 7 Antibody (KRT7/903) - IHC-Prediluted [NBP2-48139] Immunohistochemistry-Paraffin: Cytokeratin 7 Antibody (KRT7/903) - IHC-Prediluted [NBP2-48139]](https://resources.bio-techne.com/images/products/Cytokeratin-7-Antibody-KRT7-903-IHC-Prediluted-Immunohistochemistry-Paraffin-NBP2-48139-img0003.jpg)
![Immunohistochemistry-Paraffin: Cytokeratin 7 Antibody [NBP1-88080] Immunohistochemistry-Paraffin: Cytokeratin 7 Antibody [NBP1-88080]](https://resources.bio-techne.com/images/products/Cytokeratin-7-Antibody-Immunohistochemistry-Paraffin-NBP1-88080-img0021.jpg)

![Western Blot: Cytokeratin 7 Antibody (KRT7/1198) [NBP2-44820] Western Blot: Cytokeratin 7 Antibody (KRT7/1198) [NBP2-44820]](https://resources.bio-techne.com/images/products/Cytokeratin-7-Antibody-KRT7-1198-Western-Blot-NBP2-44820-img0005.jpg)
![Western Blot: Cytokeratin 7 Antibody (5V4M10) [NBP3-16388] - Cytokeratin 7 Antibody (5V4M10)](https://resources.bio-techne.com/images/products/nbp3-16388_rabbit-cytokeratin-7-mab-5v4m10-522025125454.jpg)
![Western Blot: Cytokeratin 7 Antibody (KRT7/760 + KRT7/903)Azide and BSA Free [NBP2-47942] Western Blot: Cytokeratin 7 Antibody (KRT7/760 + KRT7/903)Azide and BSA Free [NBP2-47942]](https://resources.bio-techne.com/images/products/Cytokeratin-7-Antibody-KRT7-760-+-KRT7-903-Azide-and-BSA-Free-Western-Blot-NBP2-47942-img0003.jpg)
![Western Blot: Cytokeratin 7 Antibody (KRT7/760 + KRT7/903) [NBP2-44818] Western Blot: Cytokeratin 7 Antibody (KRT7/760 + KRT7/903) [NBP2-44818]](https://resources.bio-techne.com/images/products/Cytokeratin-7-Antibody-KRT7-760-+-KRT7-903-Western-Blot-NBP2-44818-img0005.jpg)
![Western Blot: Cytokeratin 7 Antibody (KRT7/760 + OV-TL12/30)Azide and BSA Free [NBP2-47943] Western Blot: Cytokeratin 7 Antibody (KRT7/760 + OV-TL12/30)Azide and BSA Free [NBP2-47943]](https://resources.bio-techne.com/images/products/Cytokeratin-7-Antibody-KRT7-760-+-OV-TL12-30-Azide-and-BSA-Free-Western-Blot-NBP2-47943-img0004.jpg)